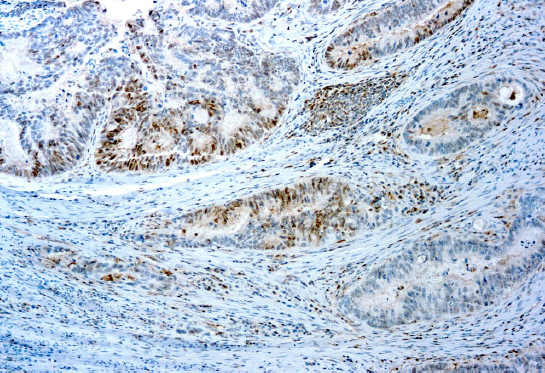

Diagnostic BioSystems launches new Rabbit polyclonal antibody
SMADs are members of the MAD-related family of molecules. MAD-related proteins are a family of intracellular proteins that are essential components in the signaling pathways of serine/threonine kinase receptors of the transforming growth factor beta superfamily. Alterations in the SMAD4 gene was primarily discovered in pancreatic cancer (duct adenocarcinoma) but occur in a variety of cancers such as colorectal cancer, gastric cancer, prostate cancer, melanomas, head and neck cancers and many others, though with higher frequencies in gastrointestinal tract cancers. Loss of SMAD4 expression in tumors has also been shown to affect cancer progression and therapy, such as reduced response to adjuvant chemotherapy.

Why Smad4?
- Is usefull in differentiating high-grade pancreatic intraepithelial neoplasia and invasive pancreatic adenocarcinoma from benign/reactive pancreas
- Loss of SMAD4 may be indicative of a pancreatic primary tumor
- Loss of SMAD4 expression in tumors has also been shown to affect cancer progression and therapy, such as reduced response to adjuvant chemotherapy
Reference
- Shi S et al. Metabolic tumor burden is associated with major oncogenomic alterations and serum tumor markers in patients with resected pancreatic cancer. Cancer Lett 360:227-33 (2015). IHC ; Human
- Shi Y, et.al. A structural basis for mutational inactivation of the tumour suppressor Smad4. Nature. 1997;388:87-93. The first crystal structure of a Smad domain, the Smad4 MH2.
Click here for the Smad 4 antibodies from Diagnostic BioSystems.